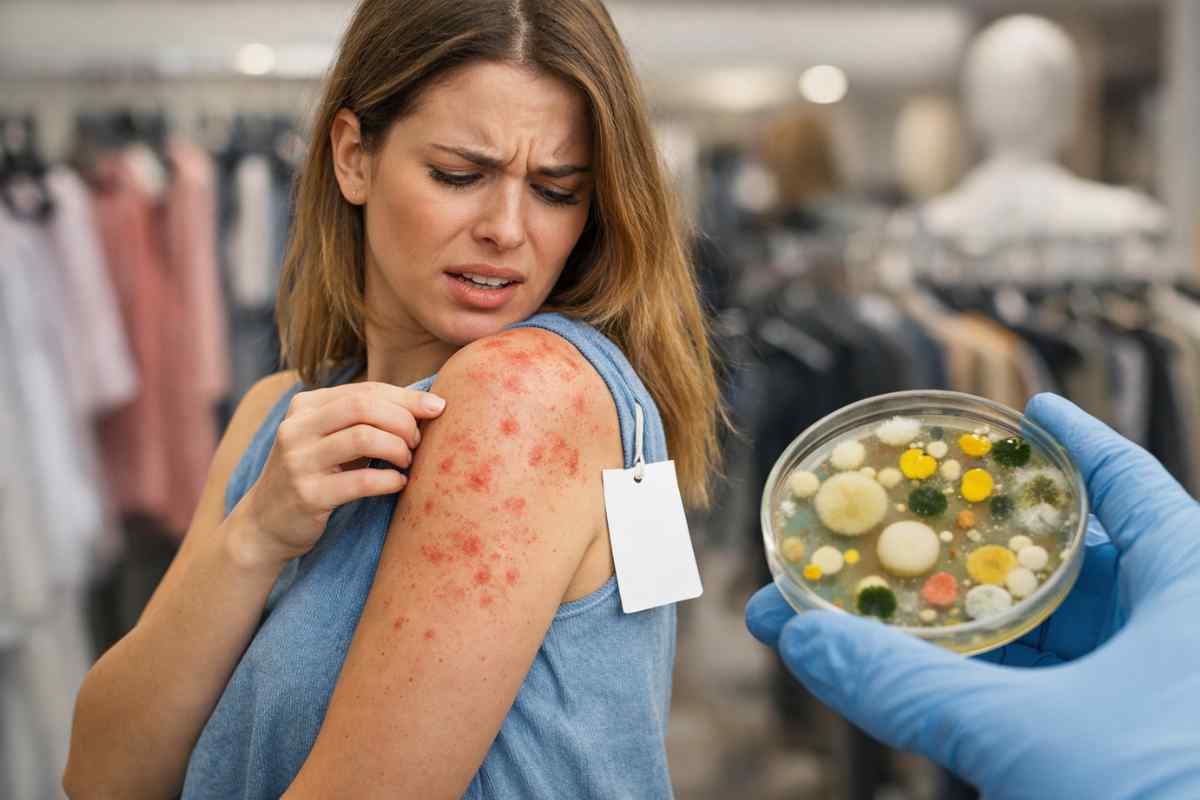

L’odore di “nuovo” che accompagna un acquisto appena uscito dal sacchetto è, per molti, parte dell’esperienza di shopping.
Quella sensazione di nitidezza cromatica e perfezione nelle pieghe suggerisce un’idea di purezza che, però, si scontra con la realtà della filiera tessile. Dietro l’aspetto impeccabile di una maglia o di un pantalone si nasconde infatti un lungo percorso fatto di trattamenti chimici, stoccaggi industriali e passaggi di mano che rendono il lavaggio preventivo una necessità igienica e sanitaria, ben lontana dal semplice eccesso di zelo.
Perché è fondamentale lavare i capi prima di indossarli
I capi che troviamo sugli scaffali non sono sterili. Durante la produzione, le fibre vengono trattate con una serie di sostanze progettate per scopi puramente estetici o logistici. La formaldeide, ad esempio, viene spesso utilizzata per evitare che i vestiti si sgualciscano durante le lunghe spedizioni transoceaniche nei container, dove l’umidità potrebbe compromettere il tessuto. A questa si aggiungono resine apprettanti, pesticidi per prevenire la proliferazione di muffe e coloranti dispersi che non sono ancora stati fissati definitivamente dal primo risciacquo.

Perché è fondamentale lavare i capi prima di indossarli (www.reteriservealpiledrensi.tn.it)
Non è un caso che i dermatologi monitorino con attenzione il fenomeno delle dermatiti da contatto. I dermatologi spiegano come l’esposizione ai residui chimici non sia un rischio da sottovalutare: le reazioni allergiche possono manifestarsi anche dopo poche ore. Le sostanze chimiche residue tendono a sciogliersi con il calore corporeo e il sudore, facilitando l’assorbimento cutaneo e scatenando arrossamenti, prurito o irritazioni più persistenti, specialmente nelle aree dove il tessuto sfrega maggiormente contro la pelle.
Oltre alla componente chimica, esiste un fattore biologico spesso ignorato. Un capo esposto in un negozio fisico può essere stato provato da decine di persone prima dell’acquisto definitivo. Questo trasforma il tessuto in un veicolo per batteri, cellule cutanee e, in rari casi, parassiti. Sebbene la carica virale o batterica tenda a diminuire nel tempo, la combinazione di agenti chimici e residui biologici di terzi rende l’indossare un capo “vergine” una scommessa poco oculata per la salute dell’epidermide.
Un dettaglio curioso riguarda i cosiddetti “finissaggi” tessili: alcune resine utilizzate per dare rigidità ai colletti delle camicie sono studiate per resistere a temperature specifiche, ed è proprio il vapore del ferro da stiro casalingo a liberare talvolta le esalazioni più intense di queste sostanze. Lavare il capo prima di stirarlo permette di eliminare gran parte di queste molecole volatili.
Il passaggio in lavatrice non serve solo a proteggere chi indossa il capo, ma offre anche una prima indicazione sulla qualità della tintura. Spesso, durante il primo lavaggio, l’acqua di scarico rivela l’eccesso di pigmenti che, altrimenti, sarebbe finito direttamente sui pori della pelle. Nella maggior parte dei casi, un lavaggio rapido a 30 o 40 gradi con una piccola quantità di detergente è sufficiente per abbattere la carica chimica e rendere il tessuto sicuro per il contatto prolungato con il corpo. È un gesto semplice che interrompe la continuità tra la chimica industriale e la nostra barriera cutanea.
Se fai shopping e non lavi i capi prima di indossarli SEI IMPAZZITO: i dermatologi sono chiari, rischi inquietanti (www.reteriservealpiledrensi.tn.it)
Se fai shopping e non lavi i capi prima di indossarli SEI IMPAZZITO: i dermatologi sono chiari, rischi inquietanti (www.reteriservealpiledrensi.tn.it)






